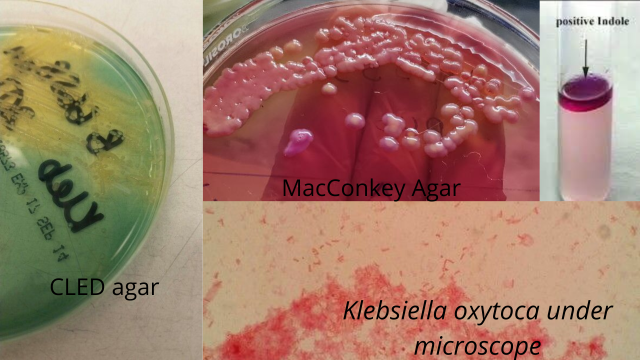
Distinguishing properties of Klebsiella oxytoca - Some distinguishing properties ofKlebsiella oxytoca

Klebsiella oxytoca belongs to the genus Klebsiella and the family Enterobacteriaceae. It is a Gram-negative rod-shaped bacteria. Klebsiella oxytoca was named Bacterium oxytocum by Flugge in 1866, because it was generally isolated from the environment. It is the second most prevalent species of Klebsiellaand has been associated with antibiotic-resistant and hospital-acquired infections.
Klebsiella oxytocais a gram-negative, capsulated, non-sporulating rod (bacilli). Some strains of the bacteria can also produce an enzyme, extended-spectrum beta-lactamases like Klebsiella pneumoniae, the most prevalent species of the genus.
General Properties ofKlebsiella oxytoca
The general properties of the bacteria are as follows:
- Gram-negative
- Rod-shaped
- Non-sporulating
- Facultative anaerobe
- Catalase positive
- Oxidase negative
- Capsulated
- Non-motile
- Opportunistic pathogen, found in soil
Virulence Factor ofKlebsiella oxytoca
- Capsule: The capsule of Klebsiella oxytocaforms from acidic polysaccharides. These capsules form thick bundles of the fibrous covering surrounding the bacterial surface in huge layers. These protect from phagocytosis.
- Pili (type 1 and type 3):Â Pili are the non-flagellar and filamentous structures on the surface of bacteria. It is also known as fimbriae. Type 1 Pili are MSHA (mannose-sensitive hemagglutinin) and help in attachment to the mannose-rich glycoprotein of the host. Type 3 Pili can attach to endothelial and epithelial cells. Type 3 Pili also has a strong affinity toward heat-treated erythrocytes.
- LPS (lipopolysaccharide): LPS is a cell wall component present in the bacteria that protects the bacteria from the immune response of the host. It also helps in establishing septicemia.
- Siderophores: Siderophores are the iron chelators that can take up the already bound iron from the host cell. Since iron is another compound after carbon necessary for the growth of these bacteria, siderophores play a considerable role in causing infections.
Pathogenesis
Klebsiella oxytoca is ubiquitous but the diseases caused by the bacteria are usually transmitted nosocomially. The hands of hospital staff and equipment used in the hospital are the main reservoirs for Klebsiellainfections.
The first step of disease is the attachment of bacteria with the help of pili. Then, the bacteria avoid different bactericidal effects of the human immune system with the help of lipopolysaccharide that provides resistance to complement proteins. Likewise, the capsule protects the bacteria from phagocytosis. Instead of engulfing and destroying the bacteria, phagocytic cells provide the environment for the bacteria to grow and multiply. Klebsiella oxytoca then colonizes the mucosal layer of the host and proceeds to infect different systems like the urinary tract and respiratory tract.
Infections
Klebsiella oxytoca is an opportunistic pathogens that causes serious hospital-acquired infections in adults, immunocompromised individuals, and neonatal. It has been prominent cause of pneumonia, UTI (urinary tract infection), soft tissues infections and septicemia that can progress to septic shock.
Laboratory Diagnosis of Infections
Sample
Urine, blood, swab, sputum, BAL (bronchoalveolar lavage), and CSF (cerebrospinal fluid) can be samples of choice depending upon the infection caused.
Sample Processing
Culturing and microscopic observation is the standard practice for processing the sample to identify bacteria.
- Microscopy:
The organism appears red-colored and rod-shaped after gram staining.
- Culture:
The samples are cultured in MacConkey agar, blood agar, and CLED agar.
Colony morphology ofKlebsiella oxytoca
- MacConkey agar: Mucoid, lactose fermenting (pink/pink-yellow) colonies.
- Blood agar: Non-hemolytic, mucoid, cream to yellow colored colonies.
- CLED (cystine lactose electrolyte deficient) agar: Mucoid, lactose fermenting yellowish white-colored colonies.
Biochemical Properties ofKlebsiella oxytoca
Note: The indole test is the distinguishing biochemical test betweenKlebsiella pneumoniae, indolenegative, andKlebsiella oxytoca, indole positive.
| Name of the test | Result |
|---|---|
| Catalase test | Positive |
| Oxidase test | Negative |
| Indole test | Positive |
| Methyl red (MR) test | Variable (20% positive) |
| Voges Proskauer (VP) test | Positive |
| Citrate utilization test | Positive |
| Urease test | Positive |
| ONPG (O-nitrophenyl-beta-D-galactopyranoside) test | Positive |
| Ornithine decarboxylase test | Negative |
| Lysine decarboxylase test | Positive |
| Malonate test | Positive |
| TSI (triple sugar iron) test | Acid/Acid gas + H 2 S – |
Treatment of Infections byKlebsiella oxytoca
The bacteria has been associated with MDR due to its characteristic feature of producing ESBL, so the treatment of choice is usually carbapenem. But proper antibiotic susceptibility testing is necessary before prescribing the antibiotics for treatment.
References and further reading
- Podschun, R., & Ullmann, U. (1998). Klebsiella spp. as Nosocomial Pathogens: Epidemiology, Taxonomy, Typing Methods, and Pathogenicity Factors. Clinical Microbiology Reviews, 11(4), 589-603. https://doi.org/10.1128/cmr.11.4.589
- Parija, S. (2012). Textbook of Microbiology and Immunology (2nd ed., pp. 261-263). ELSEVIER.
- Madiga, M., Martinko, J., Stahl, D., & Clark, D. (2012). Brock Biology of Microorganisms (13th ed., p. 882). Pearson Education.